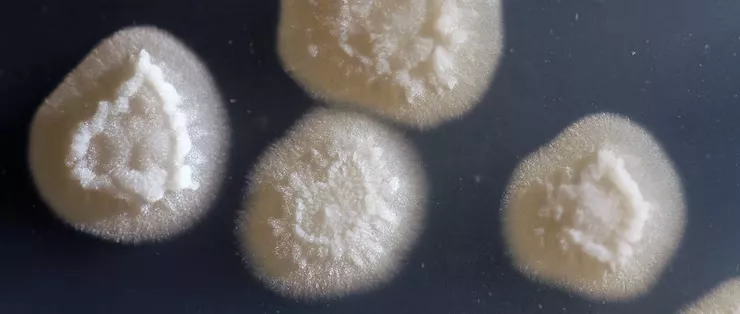
ifd58 kwwjj

Scan the WeChat code to contact us

Scan the WeChat code to contact us



全球能源系统仍依赖化石燃料,而化石燃料仍占总消费的约83%,而可再生能源所占比例远小于此。预计到2050年,需求将增长25%至50%,加剧了寻找低碳替代方案的压力。
生物柴油长期以来一直是这一探索的一部分,但第一代原料如大豆和棕榈油引发了对土地利用和粮食安全的担忧。美国国家研究中心公报最近的一项综合综述将油状真菌定位为这一不断变化的生态环境中一种可信且可扩展的替代方案。
油性真菌是能够将超过20%干生物量作为脂质积累的微生物;在优化条件下,某些菌株可达到70-80%。如莫蒂雷拉属、莫科尔属和伞形属等属已证明其产量可与油籽作物匹敌,并在每生物量上与微藻竞争。

从实际角度看,这意味着相当一部分真菌细胞可以转化为适合生物柴油的油。这些脂质富含C16和C18脂肪酸:决定燃料行为的碳原子链。对于非专业人士来说,这种成分转化为具有可接受粘度和十六烷值的生物柴油,无需大量化学升级即可满足国际燃料标准。
与作物不同,真菌不需要耕地,可以在受控的生物反应器中全年生长。与藻类不同,它们不依赖光照。它们依赖低成本基质,包括木质纤维素残留物和工业废水。这种灵活性与循环生物经济模式高度契合,废弃物成为原料而非处置责任。
综述描绘了从传统基于培养的分离向分子和基因组技术的进展。经典的镀金方法在获取活菌方面仍然有用,但受限于生长缓慢且偏向易于培养的物种。
现代方法,如基因条形编码、多位点序列分型,甚至基于CRISPR的诊断,将检测范围扩展到培养皿上生长的范围之外。简单来说,研究人员现在可以直接从环境DNA中识别真菌,包括那些抗拒实验室培养的真菌。高通量筛选工具,包括微板分析和基于荧光的脂质染色,使得数百种菌株的油品生产率能够快速比较。
这些工具已鉴定出具有工业潜力的酵母,包括Yarrowia lipolytica和Rhodotorula toruloides,这些生物能够将有机废物转化为富含脂质的生物量。瓶颈不再仅仅是发现,而是从实验室筛选转化为试点规模发酵。
真菌脂质的积累通常在高碳、低氮条件下被触发。当氮变得极限时,细胞代谢会将多余的碳转化为三酰甘油:能量密度高的储存分子。对于普通读者来说,这是一种代谢开关:生长减缓,油脂储存加速。
下游则通过溶剂基或更环保的方法,如超临界CO₂和酶辅助提取提取脂质。随后,石油通过转酯化转化为生物柴油,这是一种用短链醇替代甘油,生成燃料级酯类的化学工艺。
搅拌罐或气运生物反应器的浸没发酵实现了可控且可扩展的生产。与按月计的植物栽培周期相比,真菌生长周期以天计。这一差异对供应稳定性和工业规划有重要影响。
综述强调,油性真菌在多个方面优于传统原料:生长速率、底物柔韧性、污染风险降低以及副产物潜力。酶、有机酸和营养脂质可与生物柴油一同回收,提升整体经济效益。
挑战依然存在。在商业规模上,规模化、工艺优化和经济竞争力尚未解决。基因工程、改进的生物反应器设计和集成生物炼油厂被认为是推动因素。
油状真菌不太可能取代所有生物柴油原料。然而,随着土地限制加剧和废弃物流积累,它们结合的生物效率与工业兼容性值得认真关注。在脱碳经济中,最小的生物可能提供一些最具适应性的工具。